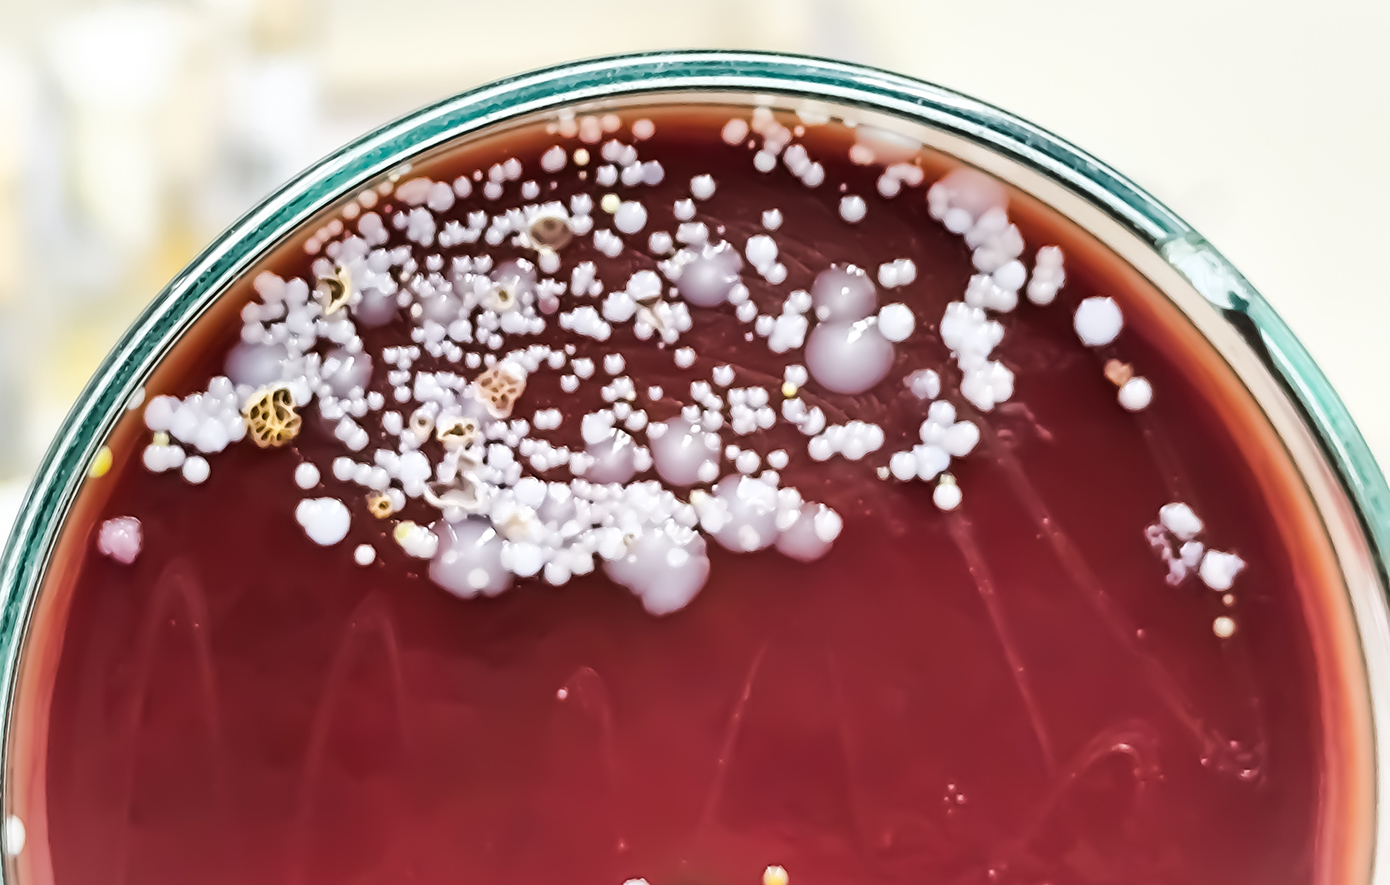

Η Νέα Υόρκη βρίσκεται αντιμέτωπη με μια αυξανόμενη απειλή δημόσιας υγείας, καθώς επικίνδυνοι μικροοργανισμοί, γνωστοί ως «superbugs», εξαπλώνονται και παρουσιάζουν ανθεκτικότητα στις υπάρχουσες θεραπείες. Ανάμεσά τους, ο μύκητας Candida auris προκαλεί ιδιαίτερη ανησυχία, καθώς επιβιώνει σε επιφάνειες ακόμη και μετά τον καθαρισμό, συχνά δεν ανταποκρίνεται στις συνήθεις αντιμυκητιασικές θεραπείες και μπορεί να οδηγήσει σε θανατηφόρες λοιμώξεις του αίματος.
Η πολιτεία της Νέας Υόρκης καταγράφει σταθερή αύξηση των περιστατικών Candida auris από το 2016, όταν και ανιχνεύθηκε επίσημα για πρώτη φορά. Μόνο το περασμένο έτος, καταγράφηκαν 623 κλινικά περιστατικά, δηλαδή ασθενείς που νόσησαν, καθώς και 849 περιστατικά επιτήρησης, που αφορούν άτομα τα οποία βρέθηκαν θετικά στον μύκητα χωρίς να εμφανίζουν συμπτώματα.
Σύμφωνα με μελέτη του προηγούμενου έτους, η μητροπολιτική περιοχή Νέας Υόρκης/Νιου Τζέρσεϊ αντιστοιχεί σχεδόν στο 20% των συνολικών περιστατικών Candida auris στις Ηνωμένες Πολιτείες. Οι ερευνητές εντόπισαν ως βασική αιτία της αύξησης τα υψηλά επίπεδα ταξιδιών και εμπορίου με τη Νότια Ασία.
Ωστόσο, το Candida auris δεν αποτελεί τη μοναδική απειλή. Ιατρικοί ειδικοί προειδοποιούν ότι η υπερβολική χρήση αντιβιοτικών συμβάλλει στην εμφάνιση «εφιαλτικών βακτηρίων», τα οποία έχουν αναπτύξει ανθεκτικότητα στα περισσότερα γνωστά φάρμακα. Ο Δρ Άαρον Γκλατ, καθηγητής και πρόεδρος του Τμήματος Ιατρικής στο Mount Sinai South Nassau, δήλωσε στη nypost ότι η χρήση αντιβιοτικών σε ιογενείς λοιμώξεις είναι όχι μόνο αναποτελεσματική αλλά και επικίνδυνη.
Όπως εξήγησε, όταν κάποιος πάσχει από ιογενή νόσο, όπως ένα κοινό κρυολόγημα του αναπνευστικού, τα αντιβιοτικά δεν προσφέρουν κανένα όφελος, ενώ αυξάνουν τον κίνδυνο τοξικότητας, παρενεργειών και κυρίως την ανάπτυξη ανθεκτικότητας. Τόνισε ότι η σωστή χρήση των αντιβιοτικών αποτελεί κρίσιμη ευκαιρία για την προστασία της δημόσιας υγείας.
Τα αντιβιοτικά προορίζονται για τη θεραπεία ή την πρόληψη βακτηριακών λοιμώξεων, όπως η στρεπτοκοκκική φαρυγγίτιδα, οι λοιμώξεις του ουροποιητικού συστήματος και η βακτηριακή πνευμονία. Αντίθετα, δεν θα πρέπει να χρησιμοποιούνται για ιογενείς λοιμώξεις, όπως το κοινό κρυολόγημα, η γρίπη, η COVID-19 ή οι περισσότερες περιπτώσεις πονόλαιμου, καθώς δεν έχουν καμία αποτελεσματικότητα και ενισχύουν την ανθεκτικότητα των μικροβίων.
Η ανθεκτικότητα των βακτηρίων στα αντιβιοτικά αναπτύσσεται κυρίως μέσω φυσικών γενετικών μεταλλάξεων, ενώ τα ανθεκτικά στελέχη μεταδίδουν το γενετικό τους υλικό σε άλλα βακτήρια. Σύμφωνα με στοιχεία του Παγκόσμιου Οργανισμού Υγείας, το περασμένο φθινόπωρο διαπιστώθηκε ότι μία στις έξι βακτηριακές λοιμώξεις ήταν ανθεκτική στις κοινές αντιβιοτικές θεραπείες, ενώ η ανθεκτικότητα αυξήθηκε κατά μέσο όρο από 5% έως 15% ετησίως την περίοδο 2018–2023.
Το πρόβλημα επιδεινώθηκε σημαντικά κατά τη διάρκεια της πανδημίας COVID-19, όταν πολλοί ασθενείς με ήπια ή μέτρια συμπτώματα έλαβαν αντιβιοτικά χωρίς να είναι απαραίτητο. Όπως σημείωσε ο Δρ Γκλατ, αυτό οφείλεται τόσο στην απαίτηση των ασθενών για αντιβιοτικά όσο και στην ευθύνη των γιατρών να αρνούνται τη χορήγησή τους όταν δεν ενδείκνυνται.
Παρά την ανησυχητική εικόνα, υπάρχουν και ενθαρρυντικά στοιχεία. Αν και το Candida auris έχει γίνει πιο διαδεδομένο στη Νέα Υόρκη, μεταδίδεται κυρίως σε δομές υγειονομικής περίθαλψης, όπως οίκοι ευγηρίας και νοσοκομεία. Ο Δρ Γκλατ διευκρίνισε ότι δεν αποτελεί σοβαρή απειλή για τον μέσο πολίτη, αλλά είναι ιδιαίτερα επικίνδυνο για ασθενείς σε τέτοιες δομές, ειδικά για όσους λαμβάνουν πολλαπλά αντιβιοτικά ή είναι ανοσοκατεσταλμένοι.

Επιπλέον, νέα φάρμακα έχουν δείξει αποτελεσματικότητα απέναντι σε ορισμένα ανθεκτικά βακτήρια, όπως το Escherichia coli και το Klebsiella pneumoniae. Την ίδια στιγμή, διακομματική ομοσπονδιακή νομοθετική πρωτοβουλία, που προτάθηκε αρχικά το 2020 και επανεισήχθη τον περασμένο μήνα, στοχεύει στην ενίσχυση της ανάπτυξης νέων αντιβιοτικών.
Ο νόμος PASTEUR (Pioneering Antimicrobial Subscriptions to End Upsurging Resistance) προβλέπει την αποζημίωση των φαρμακευτικών εταιρειών με βάση την αξία και την καινοτομία των νέων αντιβιοτικών και όχι τον όγκο πωλήσεων. Το μοντέλο αυτό, που παρομοιάζεται με συνδρομητική υπηρεσία τύπου Netflix, επιδιώκει να σταθεροποιήσει την αγορά και να ενθαρρύνει την έρευνα.
Όπως εξήγησε ο Δρ Γκλατ, το συγκεκριμένο μοντέλο προβλέπει ότι η κυβέρνηση θα καταβάλλει ένα σταθερό ποσό στις φαρμακευτικές εταιρείες για την πρόσβαση στα αντιβιοτικά, ανεξαρτήτως της χρήσης τους. Με αυτόν τον τρόπο διασφαλίζεται επαρκής αποζημίωση για την έρευνα και ανάπτυξη, ενώ παράλληλα αποφεύγεται η αύξηση του κόστους σε περίπτωση ευρείας χρήσης των φαρμάκων.